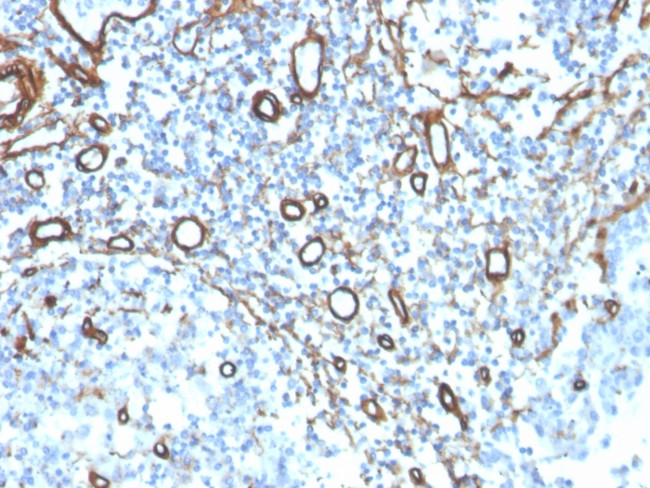
Collagen IV Antibody in Immunohistochemistry (Paraffin) (IHC (P))

Search
NeoBiotechnologies
Collagen IV Recombinant Rabbit Monoclonal Antibody (COL4, 4241R)
{{$productOrderCtrl.translations['antibody.pdp.commerceCard.promotion.promotions']}}
{{$productOrderCtrl.translations['antibody.pdp.commerceCard.promotion.viewpromo']}}
{{$productOrderCtrl.translations['antibody.pdp.commerceCard.promotion.promocode']}}: {{promo.promoCode}} {{promo.promoTitle}} {{promo.promoDescription}}. {{$productOrderCtrl.translations['antibody.pdp.commerceCard.promotion.learnmore']}}
产品信息
1282-RBM1-P1ABX
种属反应
宿主/亚型
Expression System
分类
类型
克隆号
抗原
偶联物
形式
浓度
规格
纯化类型
保存液
内含物
保存条件
运输条件
产品详细信息
Immunohistochemistry (PFA fixed): incubate antibody for 30 min RT. Staining of formalin-fixed tissues requires heating tissue sections in 10mM Tris with 1mM EDTA, pH 9.0, for 45 min at 95 degrees C followed by cooling at RT for 20 minutes.
靶标信息
Collagen IV is a type of collagen protein that is a major component of the basement membrane in various tissues, including the kidneys, lungs, and skin. It forms a network-like structure that provides support and stability to the surrounding tissue. Collagen IV is composed of three alpha chains, which are encoded by the COL4A1, COL4A2, and COL4A3 genes. Mutations in these genes can lead to various genetic disorders, such as Alport syndrome and Goodpasture syndrome, which affect the kidneys and lungs, respectively.
仅用于科研。不用于诊断过程。未经明确授权不得转售。
篇参考文献 (0)
生物信息学
蛋白别名: a matrix-derived inhibitor of angiogenesis and tumor growth; a3(IV)NC1; arresten; canstatin; COL4A1 NC1 domain; COL4A2 NC1 domain; COL4A3 NC1 domain; Collagen 4; Collagen alpha-1(IV) chain; collagen alpha-2 type IV; Collagen alpha-2(IV) chain; Collagen alpha-3(IV) chain; Collagen alpha-4(IV) chain; Collagen alpha-5(IV) chain; Collagen alpha-6(IV) chain; collagen IV, alpha-1 polypeptide; collagen IV, alpha-3 polypeptide; Collagen IV, alpha-4 polypeptide; collagen IV, alpha-5 polypeptide; collagen IV, alpha-6 polypeptide; collagen of basement membrane, alpha-1 chain; collagen of basement membrane, alpha-4 chain; collagen of basement membrane, alpha-5 chain; collagen of basement membrane, alpha-6; collagen type IV alpha 5 chain; collagen, type IV, alpha 3 (Goodpasture antigen); collagen, type IV, alpha 4; collagen, type IV, alpha 5; collagen, type IV, alpha 6; contains COL4A1 NC1 domain; dA149D17.3; dA24A23.1; dJ889N15.4 (Collagen Alpha 6(IV)); Goodpasture antigen; matrix-derived inhibitor of angiogenesis and tumor growth; non-collagenous 1 domain from alpha 1 chain of type IV collagen; pro-alpha-1(IV); procollagen alpha-1 type IV; soluble Col4A1 protein; structural non-collagenous NC1 domain; a6[IV]NC1; tumstatin; Type IV Collagen; unnamed protein product
基因别名: ASLN; ATS; ATS1; ATS2; ATS3; ATS3A; ATS3B; BFH; BFH1; BFH2; BSVD; BSVD1; BSVD2; CA44; CA54; COL4A1; COL4A1s; COL4A2; COL4A3; COL4A4; COL4A5; COL4A6; CXDELq22.3; DELXq22.3; DFNX6; ICH; PADMAL; POREN2; RATOR
UniProt ID: (Human) P02462, (Human) P08572, (Human) Q01955, (Human) P53420, (Human) P29400, (Human) Q14031
Entrez Gene ID: (Human) 1282, (Human) 1284, (Human) 1285, (Human) 1286, (Human) 1287, (Human) 1288